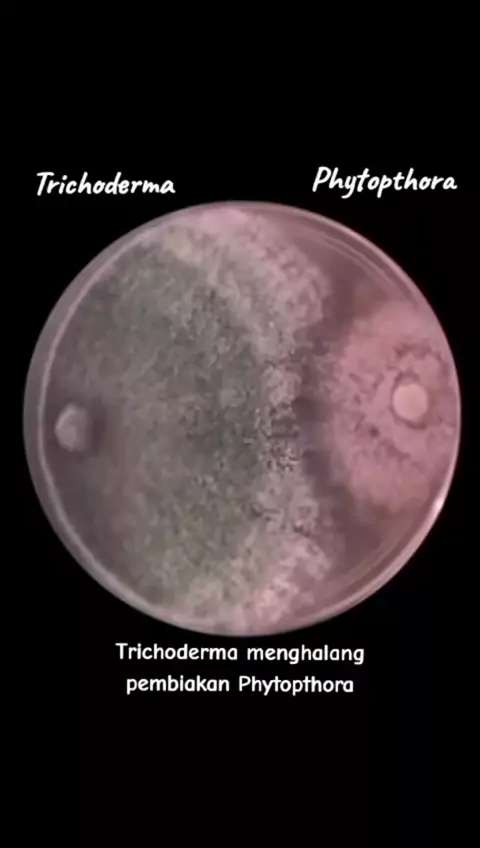

nasir968

430
Posts

All playlists · Total 24

2
Pupuk kompos di rumah menipis,kita gas buat 1 ton lagi #edukasipertanian #belajarbertanibersamamilfar #pupukkompos

3
Belajar menanam sawi caisim di rumah,untuk keperluan konsumsi keluarga ataupun untuk di jual 🥬 #belajarbertanibersamamilfar #milfaracademy

2
Kita usahakan rumah itu,dari depan tampak sederhana,tapi kebun luas ,tanaman yang mewah megah 😋 #belajarbertanibersamamilfar #berkebun

11
Penyemprotan kalsium untuk mencegah terjadinya penyakit blossom and root (busuk pada bagian bawah buah tomat ) #belajarbertanibersamamilfar #panentomat #tanamtomat #menanamtomat

2
Challanges olah lahan di tanah yang ketergantungan pupuk kimia ,lengkapnya akan kita upload di milfar id #belajarbertanibersamamilfar #berkebundirumahaja

2
Petikan ke 3 masih rimbun buahnya 🤩🌱 #belajarbertanibersamamilfar #panentomat #tanamtomat

2
Hidup dengan bertani terjamin gk sih ? 🤔 #petanimuda #petaniindonesia🇮🇩🇮🇩🇮🇩🌿🌿

2
Karna semua berawal dari tanah !! #masterhumat #mastertrico #tricoderma #asamhumat

2
Sebaiknya jangan gegabah #fakultaspertanian #agroteknologi #mahasiswapertanian

2
...

5
Udah pernah tanam strawbery gk dek? Tanam ya dek ya,rasanya manis asem seeegeerrr🤩 #strawberry #tanamstrawberrydihalamanrumah #tanamstrawberry

2
Ciptakan ketahanan pangan dari rumah, kamu kapan ?? yuk manfaatkan lahan sebaik mungkin #serunyaberkebundirumah #minigarden #kebunmini #serunyaberkebun #ciptakanketahananpangandarirumah ,#berkebundirumahaja

2
update cabai salah satu peserta pelatihan budidaya cabai milfar_id , milik akun @lotenggarden ciptakan ketahanan pangan dari rumah 💪🏼 kamu kapan ??? #petanicabai #cabaidipolybag #cabaidirumah #serunyaberkebun #ketahananpangan

2
Update penanaman kacang tanah 15 Hst, Ada yang tanam kacang tanah juga? #kacangtanah #petanikacangtanah #petaniindonesia🇮🇩🇮🇩🇮🇩🌿🌿

4
Membalas @sachio654 Belajar menanam cabai dari 0 YUK JOIN KELAS BUDIDAYA, VIDIO PEMBELAJARAN LENGKAP, DAN JUGA DI MENTORIN BIAR KAMU PUAS BERTANYA, KONTAK KAMI ADA DI PROFILE (083134083929) #petanicabaiindonesia #bertanicabai #menanamcabai #belajarmenanamcabai

4
Masa hidup cabai di polybag #petanicabai🌶️🌶️🌶️ #berkebundirumahaja #menanamcabai #cabaidipolibag #mediatanamcabai #polybagcabai

4
buat kamu yang punya produk syngenta,jangan di anggurin yuk buat vidio kreatif pengalaman menarik kamu bersama syngenta dan ikutan#CeritaSyngentaku Jangan lupa pakai hashtag#SyngentaXMilfar juga ya. untuk info lebih lanjut cek sosial media Syngenta, Di tunggu cerita menariknya!😉@Syngenta Rumah Tani Indonesia

2
Membalas @ethanlee288 Semoga terjawab ya 😅#serunyabelajar#edukasimilfar_id#petanicabai🌶️🌶️🌶️#bertaniitukeren#petanimudasukses

2
Pilih potong pucuk apa enggak kira kira untung mana ya ??🤔#edukasimilfar_id #serunyabelajar #petanikeren #petanicerdas #bertaniitukeren #petanicabai🌶️🌶️🌶️ #potongpucukcabai

2
Membalas @ال عمران Semoga terjawab ya,follow dan pantau terus sosial media Milfar_id untuk mendapatkan informasi menarik lainnya seputar bidang pertanian 😁#milfar_id#edukasimilfar_id#petanimudasukses#bertaniitukeren#petanikeren#petanicerdas